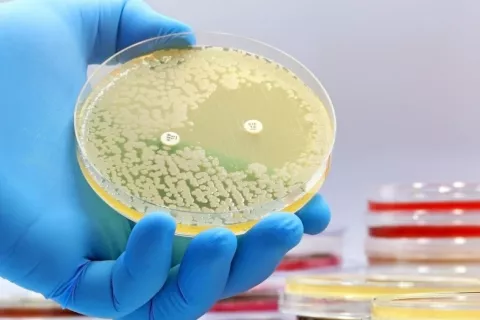

La OMS alerta de la creciente resistencia a los antibióticos en todo el mundo
13/10/2025
Uno de cada seis casos de infecciones bacterianas comunes confirmadas en laboratorio en 2023 fue resistente a los tratamientos con antibióticos, según un nuevo informe de la Organización Mundial de la Salud (OMS)1, que revela que entre 2018 y 2023 la resistencia a los antibióticos aumentó en más del 40% de las combinaciones de bacterias y medicamentos analizadas, con un incremento medio anual del 5 al 15%.
Los datos procedentes de más de 100 países, recopilados por el Sistema Mundial de Vigilancia de la Resistencia y el Uso de Antimicrobianos (GLASS), alertan de que la creciente resistencia a los antibióticos esenciales supone una amenaza cada vez más grave para la salud global.
El Informe Mundial de Vigilancia de la Resistencia a los Antibióticos 2025 ofrece por primera vez estimaciones sobre la prevalencia de la resistencia frente a 22 antibióticos empleados en el tratamiento de infecciones urinarias, gastrointestinales, de la sangre y de transmisión sexual como la gonorrea. El análisis incluye ocho patógenos bacterianos frecuentes: Acinetobacter spp., Escherichia coli, Klebsiella pneumoniae, Neisseria gonorrhoeae, Salmonella spp. no tifoidea, Shigella spp., Staphylococcus aureus y Streptococcus pneumoniae.
Factores que contribuyen al aumento de la resistencia antimicrobiana
Según la OMS, la resistencia a los antibióticos es más elevada en las regiones del Sudeste Asiático y del Mediterráneo Oriental, donde una de cada tres infecciones notificadas resultó resistente al tratamiento. En África, la proporción fue de una por cada cinco infecciones. Los países con sistemas sanitarios más débiles, sin capacidad suficiente para diagnosticar o tratar infecciones bacterianas, son los más afectados.
E. coli y K. pneumoniae son las principales responsables de infecciones graves del torrente sanguíneo, que pueden derivar en sepsis, fallo multiorgánico e incluso la muerte
“La resistencia a los antimicrobianos está superando los avances de la medicina moderna, amenazando la salud de las familias en todo el mundo”, ha declarado el Dr. Tedros Adhanom Ghebreyesus, Director General de la OMS2. “A medida que los países fortalecen sus sistemas de vigilancia de la RAM, debemos usar los antibióticos de forma responsable y asegurar que todos tengan acceso a los medicamentos adecuados, diagnósticos de calidad garantizada y vacunas. Nuestro futuro también depende del fortalecimiento de los sistemas de prevención, diagnóstico y tratamiento de infecciones, así como de la innovación con antibióticos de última generación y pruebas moleculares rápidas en el punto de atención”, añade.
Las bacterias gramnegativas constituyen la mayor amenaza
El informe advierte de que las bacterias gramnegativas resistentes a los antibióticos se están convirtiendo en un grave problema a escala mundial, especialmente en los países con menos recursos. Entre ellas, E. coli y K. pneumoniae son las principales responsables de infecciones graves del torrente sanguíneo, que pueden derivar en sepsis, fallo multiorgánico, e incluso la muerte.
Más del 40% de las cepas de E. coli y más del 55% de las de K. pneumoniae ya no responden a las cefalosporinas de tercera generación, el tratamiento de primera elección para este tipo de infecciones. En África, la resistencia supera incluso el 70%. Otros antibióticos esenciales, como los carbapenémicos y las fluoroquinolonas, también están perdiendo eficacia frente a bacterias como E. coli, K. pneumoniae, Salmonella y Acinetobacter.
La resistencia a los carbapenémicos, que antes era poco frecuente, se ha vuelto cada vez más común, lo que ha reducido las opciones terapéuticas y obligado a recurrir a fármacos de último recurso que son caros, difíciles de conseguir y, en muchos países de ingresos bajos y medios, prácticamente inaccesibles.
La participación de los países en el sistema GLASS ha aumentado más de cuatro veces, pasando de 25 en 2016 a 104 en 2023. Sin embargo, casi la mitad de los países (48%) no enviaron datos ese año y muchos de los que sí lo hicieron carecen de sistemas sólidos para generar información fiable. En general, los países más afectados por la resistencia antimicrobiana son los que menos capacidad tienen para vigilarla.
En 2024, la Asamblea General de las Naciones Unidas3 adoptó una declaración política sobre la resistencia a los antimicrobianos, que establece metas para reforzar los sistemas de salud y promover un enfoque integral “Una Salud”, que aborde conjuntamente la salud humana, animal y ambiental.
La OMS insta a todos los países a presentar datos de alta calidad sobre la resistencia y el uso de antimicrobianos al GLASS antes de 2030. Para lograrlo, será necesario mejorar la calidad, cobertura geográfica y compartición de los datos, de modo que se puedan seguir los avances y adaptar los tratamientos y políticas de salud pública.
También se recomienda reforzar la coordinación entre todos los niveles del sistema sanitario y actualizar las guías clínicas y listas de medicamentos esenciales conforme a los patrones locales de resistencia. El informe se complementa con un panel digital interactivo en la plataforma GLASS de la OMS4, donde se pueden consultar los datos mundiales y regionales, perfiles de país y estadísticas detalladas sobre el uso de antimicrobianos.
En Webconsultas nos tomamos muy en serio la calidad de la información. Por eso, seleccionamos y verificamos nuestras fuentes, dándole prioridad a investigaciones avaladas por expertos, instituciones académicas de prestigio, sociedades médicas y revistas científicas reconocidas. Nuestro objetivo es ofrecerte un contenido preciso, íntegro y confiable.
- 1
(AMR), Antimicrobial Resistance Division. “Global Antibiotic Resistance Surveillance Report 2025.” World Health Organization, 13 Oct. 2025, https://www.who.int/publications/i/item/9789240116337.
- 2
World Health Organization: WHO. “WHO Warns of Widespread Resistance to Common Antibiotics Worldwide.” World Health Organization: WHO, 13 Oct. 2025, https://www.who.int/news/item/13-10-2025-who-warns-of-widespread-resistance-to-common-antibiotics-worldwide#cms.
- 3
World Health Organization: WHO. “World Leaders Commit to Decisive Action on Antimicrobial Resistance.” World Health Organization: WHO, 26 Sept. 2024, https://www.who.int/news/item/26-09-2024-world-leaders-commit-to-decisive-action-on-antimicrobial-resistance.
- 4
https://worldhealthorg.shinyapps.io/glass-dashboard/_w_3b6af0083a344c0b8a95743744e34736/#!/home
Actualizado: 13 de octubre de 2025











